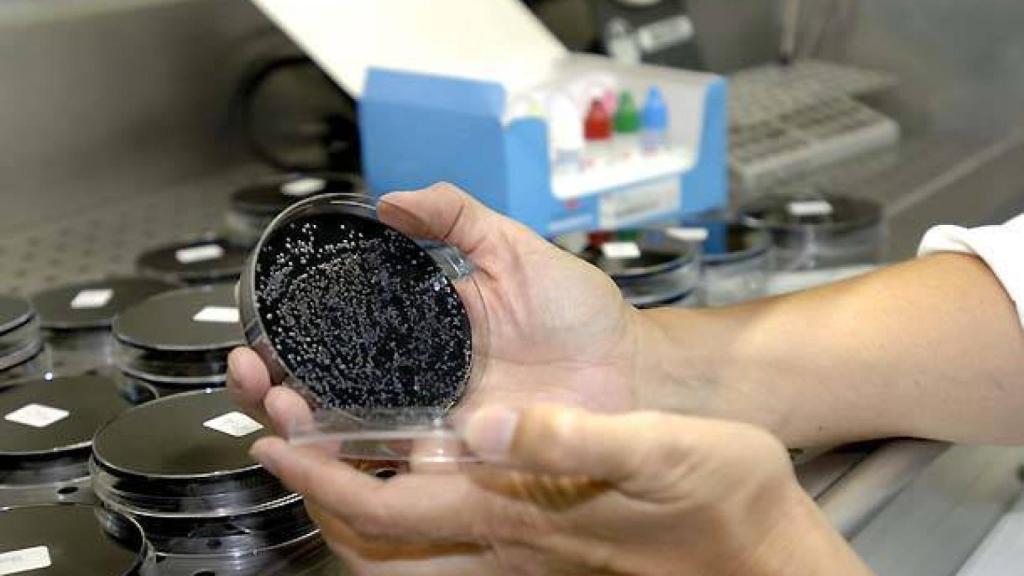
Imagen de archivo. Foto: EP

Imagen de archivo. Foto: EP
Sanidad confirma un caso de legionela en un hombre en Ciudad Real
La Consejería de Sanidad de Castilla-La Mancha ha confirmado este jueves ala agencia Efe la aparición de un "caso aislado" de contagio de legionela en Ciudad Real en un hombre que ya fue dado de alta y se encuentra en su domicilio.
Fuentes de la Consejería de Sanidad han señalado que fue precisamente a raíz de realizársele el test de hábitos que en estos casos se emplea para determinar el origen del contagio, cuando esta persona les informó que entre ellos estaba el pasear cada día por varios parques de la ciudad, donde finalmente se detectó la presencia de esta bacteria.
Según estas mismas fuentes, una vez que se tuvo conocimiento de este caso se activó el protocolo de seguridad que llevó a los técnicos de Salud Pública a realizar nuevos controles en las fuentes públicas de estos espacios, en cuatro de las cuales dio positivo en la presencia de legionela.
Mensaje de tranquilidad
Tras detectarse estos focos, han señalado las fuentes, se informó al Ayuntamiento de Ciudad Real para que procediera a aplicar el protocolo establecido en este tipo de casos. La alcaldesa de Ciudad Real, Pilar Zamora, en declaraciones este jueves a los medios de comunicación ha lanzado un mensaje de tranquilidad a la ciudadanía y ha dicho que no debe existir alarma por la presencia de la bacteria legionela en las fuentes de la ciudad.
La regidora ha asegurado que, al contrario de los rumores que han circulado por las redes sociales, está garantizado que en el agua potable del suministro no ha aparecido en ningún caso la presencia de legionela, una bacteria que "no se transmiten por el contacto con el agua ni por beberla, sino, que se trasmite por la evaporación".
Ha recordado que la aparición de esta bacteria en cuatro fuentes de la ciudad se ha producido después de que el Ayuntamiento realizara un plan de choque y de que en septiembre se realizaran los últimos controles que indicaban que era negativo la presencia de legionela en estas mismas fuentes.
Aplicación del protocolo
Asimismo, ha comentado que en cuanto se tuvo conocimiento de esta circunstancia inmediatamente se ha aplicado el protocolo establecido de vaciado de las fuentes y se ha procedido a limpiarlas, tras lo cual, en un período de 15 días se volverá a realizar un estudio de cada una de las fuentes para ver "si ha desaparecido el problema".Zamora ha insistido en la necesidad de no generar alarma a través de las redes sociales, puesto que "no es real".
A preguntas de los periodistas sobre el hecho de que este sea el segundo caso de la aparición de la bacteria de legionela que se ha detectado en Ciudad Real tras el que detectaron los Servicios Municipales del Ayuntamiento de Ciudad Real en la fuente del Pozo de Don Gil, ubicada entre las Plazas de Cervantes y el Pilar en 2016, la alcaldesa ha señalado que Ciudad Real no es una ciudad donde la legionela "tenga una principal incidencia" con respecto a otras.
Y ha reiterado que los vecinos de Ciudad Real deben de estar tranquilos, porque todos los protocolos de seguridad han funcionado adecuadamente, lo que ha permitido que se haya actuado con rapidez ante este problema.
Críticas del PP
Por su parte, el portavoz del Grupo Municipal Popular, Paco Cañizares, ha afirmado este jueves que es "intolerable" que los vecinos de Ciudad Real se hayan enterado por WhatsApp de la aparición de una cepa de legionela en cuatro fuentes de la capital, tres en el parque de Gasset y una en los Jardines del Torreón, lo que ha "generado desconfianza y una situación de alarma entre los vecinos".
Cañizares ha incidido en que el equipo de Gobierno del PSOE y Ciudadanos "ha actuado tarde", causando una grave alarma social en la ciudadanía que se hubiera evitado de haber trabajado con "diligencia y transparencia", ha informado el PP en un comunicado.
Además, ha anunciado que, ante esta falta de transparencia del equipo de Gobierno, el Grupo Municipal del PP ha presentado un escrito en el registro del Ayuntamiento solicitando información sobre cuándo han tenido conocimiento los servicios municipales de este nuevo brote de legionela en las fuentes ornamentales de la capital y en qué fecha comunicó Sanidad al Ayuntamiento la presencia de la nueva cepa.
"El equipo de Gobierno ha actuado tarde y es urgente que den explicaciones a todos los ciudadrealeños", ha indicado Cañizares, quien ha señalado que un asunto "tan grave como este no puede solventarse con un escueto comunicado del Ayuntamiento forzado por la alarma existente".
El Grupo Municipal Popular también quiere saber si el Ayuntamiento ha hecho las labores de mantenimiento y los tratamientos necesarios para evitar que se haya desarrollado esa cepa de legionela, ya que las causas de la acumulación de esa bacteria son, principalmente, la falta de mantenimiento o el mantenimiento inadecuado, ha concluido.



